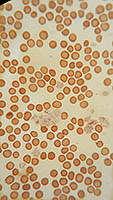

Importance of Blood Smear Evaluation
|   Anisocyotosis, hypochromasia, poikilocytosis, Howell Jolly body, Canine | |
|   Toxic band neutrophil with Dohle body | 
By Joan Gorman, RVT
Automated hematology analyzers provide reliable diagnostic information. However, microscopic evaluation of peripheral blood smears affords clinicians additional data that may be used to guide diagnosis and treatment.
Examining the monolayer of a well-prepared and properly stained blood smear allows veterinary technicians to assess erythrocyte (RBC), leukocyte (WBC) and platelet morphology. Changes to the orientation, size, shape and color of cells occurs with many disorders including anemia, neoplasia, infectious disease, inflammation, myeloproliferative disorders and bone marrow defects. These cellular changes may go unnoticed when relying on automated analyzers alone.
| Platelet Clumping, Feline | |
|   Metarubrictye, anisocytosis | 
In addition to morphology evaluation, cellular counts and estimates can be used to establish baseline values and allow monitoring of an animals progress throughout therapy. Many automated hematology analyzers do not provide a full leukocyte differential count. Reporting the relative and absolute values of segmented neutrophils, band neutrophils, lymphocytes, monocytes, eosinophils and basophils assists to differentiate between inflammation, bacterial and viral infection. For example, an increase in the absolute value of band neutrophils is defined as a left shift. This is the bone marrow’s natural response to fight infection.
Additional evaluation parameters should include scanning for immature cells, inclusions, parasites, cellular clumping and toxic changes. The presence of nucleated red blood cells in peripheral blood of mammals is indicative of bone marrow stress or damage. These immature cells may erroneously increase the total WBC count reported in automated hematology analyzers. Microscopic identification of nucleated red blood cells allows for correction of the WBC count. Intracellular inclusions and parasites may be found in both leukocytes and erythrocytes. Extracellular parasites may also be observed. Cellular clumping (e.g. platelet aggregates) results in inaccurate counts when using automated analyzers.
Although hematology analyzers provide valuable information quickly, they have limitations. Evaluating a peripheral blood smear takes very little time and is an invaluable skill. The information garnered from blood smear examination combined with automated technology results in improved patient outcomes.
Joan Gorman is a graduate Maple Woods Veterinary Technology and has been an instructor in the Maple Woods Veterinary Technology program since 2002.
|  Joan is pictured here with Nanook, a Maple Woods Vet Tech graduate. Nanook came to the program from a shelter in the spring of 2010. He was diagnosed with sebaceous adenitis. He was adopted by a graduate of the program and is doing well today! | 
         
            Next Article: Rabies Antibody Test for Pet Export—FAVN
         
         
         
            Back to Index